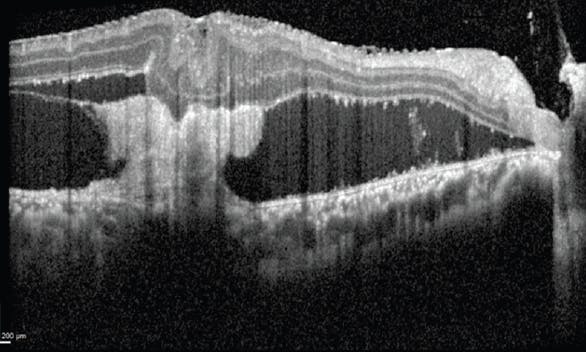

AT A GLANCE
- If another surgical team has performed the initial closure of an open globe injury, the surgeon should closely study the details of the repair when preparing for the secondary vitrectomy.
- With larger retinectomies, perfluorocarbon liquid is often useful to flatten the retina; however, in some cases a fluid-air exchange is sufficient to drain the subretinal fluid.
- Because sclopetaria injuries are full-thickness ruptures of the retina and choroid, surgeons must remember that membranes will often traverse the entire thickness of the retina; therefore, they must peel judiciously.
Managing posterior segment trauma can be daunting due to the highly variable nature, often uncertain preoperative anatomy, and increased risk of complications such as intraoperative hemorrhage and postoperative proliferative vitreoretinopathy (PVR). Although each trauma case is unique, a set of standard steps and principles can help guide surgeons through the most challenging retinal detachment (RD) repairs. The following case presentations illustrate two different retinal complications that can present after ocular trauma and the management strategies that proved successful for me.
CASE NO. 1: RD REPAIR AFTER OPEN GLOBE INJURY
An elderly man had previously experienced a zone 3 open globe injury of his right eye and had undergone primary repair. The injury was a rupture, and the scleral laceration, located at the insertion of the lateral rectus muscle, extended approximately 10 mm posteriorly in a radial fashion. The laceration was completely closed, and the lateral rectus had been disinserted and replaced during the primary repair.
Although my postoperative examinations were limited by vitreous hemorrhage, B-scan ultrasound demonstrated a temporal macula-involving RD.
In situations in which another surgical team has performed the initial closure of an open globe injury, it is important to study the details of the repair when preparing for the secondary vitrectomy. Information about the zone of injury; wound location, trajectory, and length; and whether muscles were disinserted can help surgeons predict where the retina might be incarcerated and how easily (or not) they can place a scleral buckle. Performing a detailed preoperative B-scan ultrasound is essential to identify any hemorrhagic choroidal detachments, the location of the RD, and the status of the posterior hyaloid.
Having gathered this information, I performed the secondary vitrectomy in this case in a stepwise fashion (Table). During placement of an encircling band, the lateral rectus required additional dissection of scar tissue prior to isolation due to its disinsertion at the primary repair.
Lensectomy was performed, and then vitrectomy was begun superonasally because the preoperative B-scan ultrasound had shown that the hyaloid was elevated and the retina appeared attached in this quadrant. Once the subhyaloidal space was entered, this plane was extended until the entire retina could be visualized. As expected, the retina was incarcerated temporally in the scleral wound, with elevation and temporal dragging of the macula. Diathermy was applied in confluent spots to mark the anticipated retinectomy site, and I used both vertical scissors and the vitreous cutter to complete the retinectomy and release the incarcerated retinal tissue.
With larger retinectomies, perfluorocarbon liquid is often useful to flatten the retina; in this case, however, the nature of the scleral wound allowed use of a smaller radial retinectomy that ended quite posteriorly, and a fluid-air exchange was sufficient to drain the subretinal fluid. Afterward, two to three rows of laser spots were applied to the retinectomy edge (Figure 1), and silicone oil was inserted as a tamponade.

Figure 1. Two to three rows of laser spots were applied to the edge of the retinectomy that was required to release this patient’s retina from its scleral incarceration site.
This repair was successful because I had a good understanding of the anticipated anatomy of the RD (based on my knowledge of the primary open globe repair) and a careful preoperative B-scan ultrasound.
CASE NO. 2: SCLOPETARIA-ASSOCIATED RETINAL DETACHMENT AFTER CLOSED GLOBE INJURY
A 24-year-old man presented 3 months after multiple gunshot wounds to the head and orbit with VA of 20/150 OD and no light perception OS. There was a complete inoperable RD in the left eye, with the retina adherent to the posterior lens capsule. The anterior segment examination of the right eye was normal. The dilated fundus examination of the right eye revealed extensive scarring of the posterior pole with preretinal and subretinal membranes, consistent with a sclopetaria injury (Figure 2). OCT imaging of the right eye confirmed that the retina was detached at the macula (Figure 3). Due to concern for progressive loss of vision in this patient’s only seeing eye from the tractional RD, a 25-gauge vitrectomy with membrane peel was performed.

Figure 2. Multiple gunshot wounds to the head and orbit left this patient with extensive scarring of the left eye’s posterior pole with preretinal and subretinal membranes, consistent with a sclopetaria injury.
Because sclopetaria injuries are full-thickness ruptures of the retina and choroid, surgeons must remember that membranes can often traverse the entire thickness of the retina, and therefore they must peel judiciously. Careful assessment of the preoperative OCT can help demonstrate where the membranes span the retina and aid in surgical planning.
In this case, I applied indocyanine green dye to the surface of the retina to stain the internal limiting membrane (ILM) and better delineate the plane where the epiretinal membranes (ERMs) were present. All of the ERMs were removed from the surface of the retina. In the areas where the membranes extended posteriorly through the retina into the subretinal space, I used intraocular scissors to truncate the membranes at the surface of the retina to decrease the chance of creating full-thickness breaks. The subretinal membranes were left intact under the assumption that the epiretinal traction alone had been sufficient to cause the RD and that attempts to manipulate these membranes could cause additional photoreceptor damage.
The eye was left under fluid, and within 1 month the detachment had resolved and the patient’s VA stabilized at 20/100 (Figure 4).
This case involved a tractional RD associated with sclopetaria, but rhegmatogenous RDs can also occur. In such cases, retinal breaks are often found at the edge of the sclopetaria scars.

-1_1638377570.jpg?auto=compress,format&w=70)
















